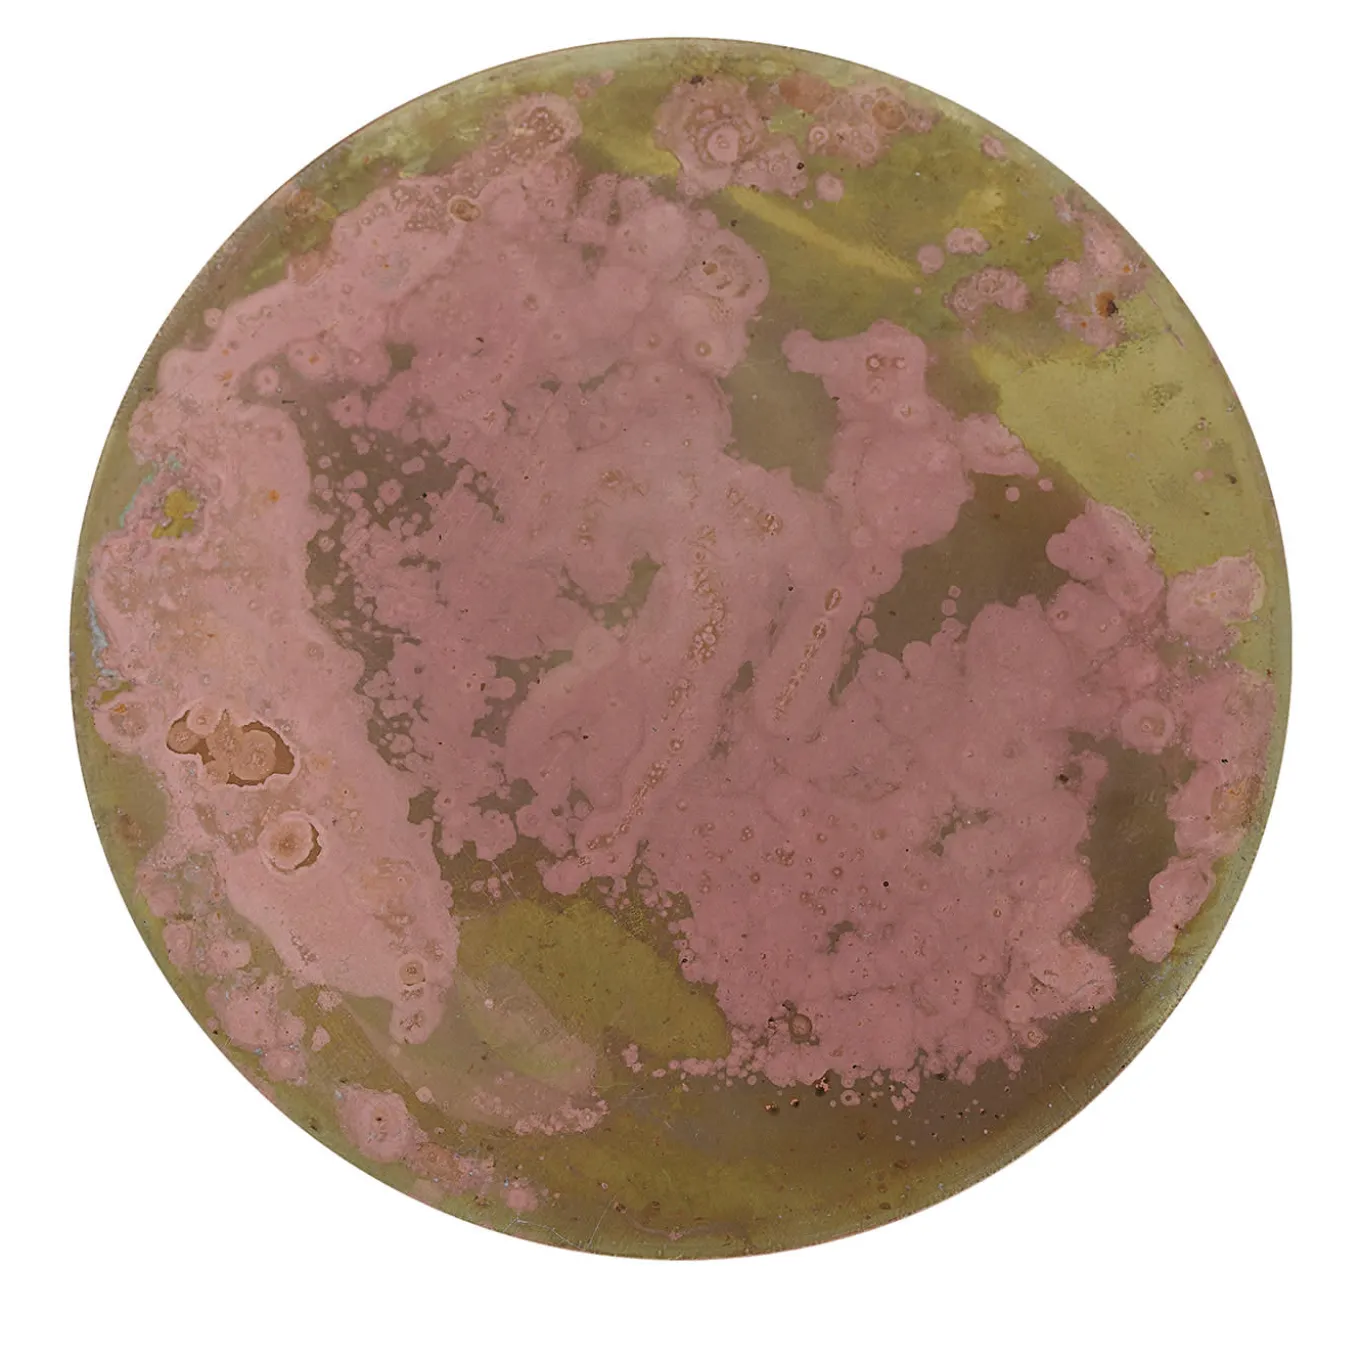
Geografie Emozionali Set of 6 Coasters #6

Geografie Emozionali Set of 6 Coasters #6
$136.89
SKU: SKUNG0MtKXWMi Categories: Coasters, Tabletop, Tabletop Accessories Tag: Pietro Spoto Studio Brand: Pietro Spoto Studio
Six brass disks artfully treated with acids and oxides up to achieve their shaded green backdrop and mottled pink design make up this exclusive set of coasters. Covered with a velvety material for optimized grip and their front protected by multiple antioxidant layers to prevent corrosion, each piece is unique, resulting from a meticulous artisan process.
MaterialBrassDimensions (in)W 4.7 x D 4.7 x H 1.2Product referenceSILSMI-073Tearsheet
Be the first to review “Geografie Emozionali Set of 6 Coasters #6” Cancel reply
Related products
Serveware
$132.89
Sale!
Serveware
Sale!
Serveware
Sale!
Sale!
Dessert Plates
$117.89
Sale!
Table Linen
Sale!
Dining Sets
Sale!
Drinking Glasses & Tumblers
Sale!
Sale!
Cocktail & Spirits Glasses
$87.89
Sale!
Sale!
Drinking Glasses & Tumblers
Dessert Plates
$134.99
Bar Accessories
$132.99
-
- Furniture
- Lighting
- Décor
- Tabletop
- Art
- Lifestyle
- Brand
- Login
- Newsletter
Login

Geografie Emozionali Set of 6 Coasters #6

Reviews
There are no reviews yet.